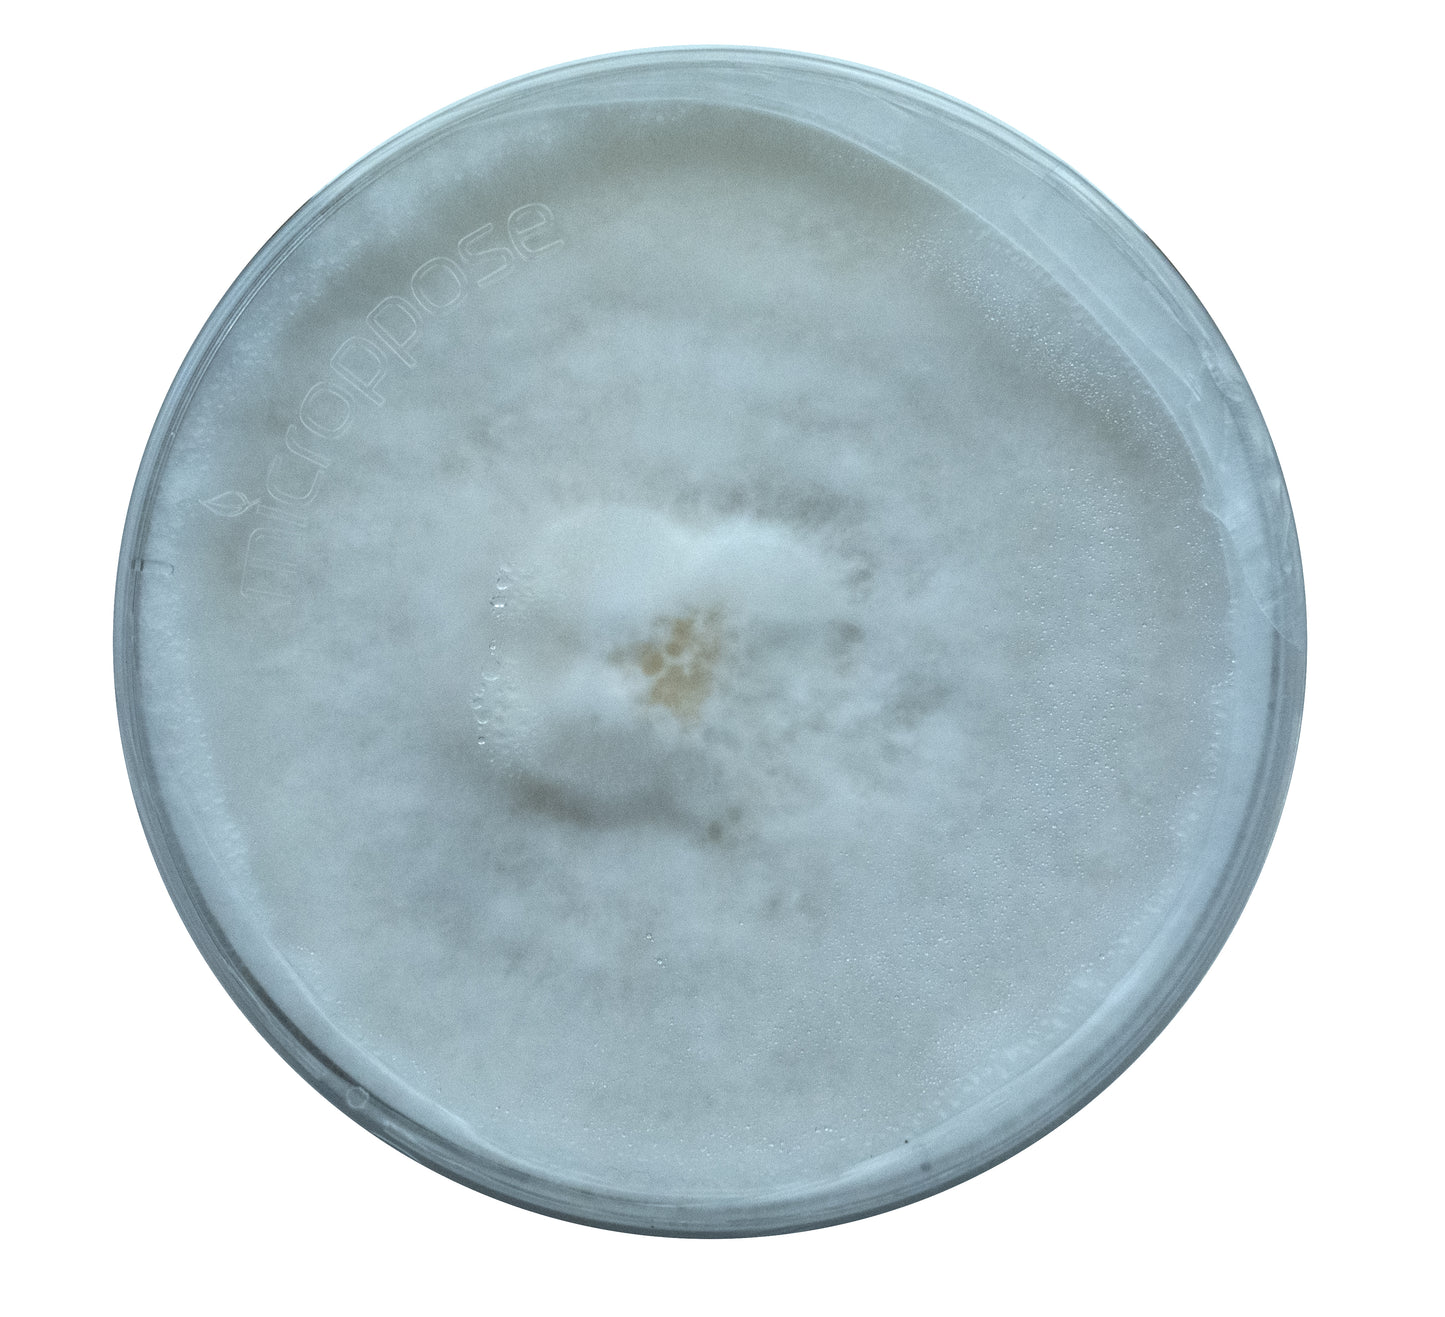
Blue Oyster Culture

1
/
of
10
Cap n Stem
Blue Oyster Culture
Blue Oyster Culture
Regular price
$75.00 USD
Regular price
Sale price
$75.00 USD
Unit price
/
per
Shipping calculated at checkout.
Beginner friendly plate
Fully colonized
Each culture comes with a complimentary duplicate
Able to inoculate up to 12 grain masters
All of the cultures we offer at Maine Cap N' Stem are stored in cryogenic deep freezers to preserve their commercial viability. Each strain is readily available but will take up to 3 weeks to transfer from cryovials to agar plates to ensure you're receiving a clean culture at its youngest possible genetic state
For more info on all our strains click here!
Couldn't load pickup availability
Share